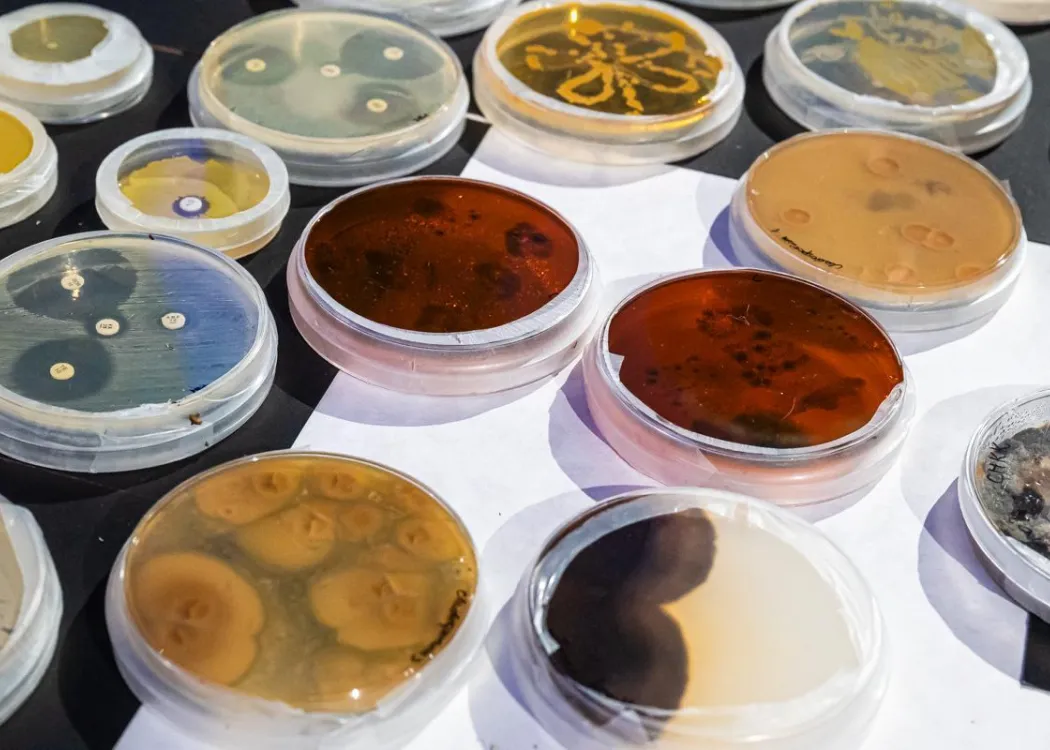
Noc Biologów 2026

17 Stycznia 2026
Aktualności
Noc Biologów to ogólnopolska inicjatywa skierowana do wszystkich zainteresowanych światem nauki. W programie coś dla siebie mogły znaleźć osoby w różnym wieku. Noc Biologów cieszy się co roku dużym zainteresowaniem. Do Kortowa przyjechały więc grupy dzieci i młodzieży z całego regionu. Przed południem zajęcia odbywały się w budynkach wydziału, po południu na chętnych gości czekała przestrzeń edukacyjna Kortosfery.
Jak co roku wydarzeniu towarzyszył określony temat przewodni. Tym razem związany był on z tym, jak różne organizmy się rozpoznają i jak zmysłami poznają świat.
Misja społeczna
Wydział Biologii i Biotechnologii w przygotowanie wydarzenia zaangażowany jest od samego początku, dlatego tegoroczna edycja była już piętnastą w Kortowie. Organizatorzy podkreślają, że łączy to ich własną fascynację biologią i naukami ścisłymi z potrzebą dzielenia się wiedzą, co jest jedną z misji uczelni.
– Prowadzenie zajęć z kimś, kto chce w zajęciach uczestniczyć, to dla nas satysfakcja i przyjemność. Widzimy radość na twarzach uczestników. Część nauczycieli przyjeżdża do nas z dziećmi i młodzieżą od lat. Pokazujemy, że biologia jest nauką ważną, ciekawą i nie taką trudną, jak się wydaje. Chcemy ją trochę odczarować, bo odpowiednio poprowadzona jest zrozumiała, dostępna. To nauka podstawowa. Bill Gates powiedział, że jednym z kierunków, który przetrwa AI, jest biologia, bo czerpiemy z niej wszyscy – mówiła dr hab. Dorota Juchno, prof. UWM, prodziekan ds. studenckich i promocji na Wydziale Biologii i Biotechnologii UWM. Przypomniała też, że zjawiska biologiczne mogą być bardzo inspirujące dla innych dziedzin: np. przewodnictwo między komórkami nerwowymi dla świata technologii czy ułożenie skrzydeł ptaków w locie dla produkcji energooszczędnych samolotów.
Już drugi raz współorganizatorem i gospodarzem popołudniowo-wieczornej części inicjatywy jest Kortosfera. Dla jej dyrektora Mateusza Pikulińskiego, absolwenta Wydziału Biologii i Biotechnologii UWM, to powód do radości. Popołudniowy program rozplanowano na dwa bloki godzinowe: 16-19 i 19-22. Na godz. 16:50 sprzedano na pierwszy blok zajęć 320 biletów, a godzinę później przekroczono wynik zeszłoroczny, bo w wydarzeniu wzięło udział 550 osób.
– Przygotowaliśmy dużo atrakcji. Dzisiaj jest premiera wystawy „Twoje ciało, Twoja planeta, Twoja wiedza”, którą realizowaliśmy podczas projektu SEED, objeżdżając szkoły w naszym województwie. Będzie ona dostępna w Kortosferze przez cały okres ferii. Zapraszamy, by uczestniczyć i dotykać nowych eksponatów, które są w obiekcie. To 14 elementów dodatkowych, rozmieszczonych na wszystkich piętrach. Temat jest bardzo szeroki: jest fizyka, biologia, mikrobiologia. Wystawa m.in. buduje świadomość na temat żywienia, ile cukru jest w niektórych produktach, które spożywamy. Zaprojektowaliśmy tę wystawę sami z dr. Tomaszem Bałabańskim – mówił „Wiadomościom Uniwersyteckim” w dniu wydarzenia Mateusz Pikuliński, dyrektor Kortosfery. – Cieszy nas współpraca z Wydziałem Biologii i Biotechnologii i udział w dzisiejszym wydarzeniu. Zależało mi, by „rozruszać” Noc Biologów. Myślę, że format i dostępność obiektu Kortosfery jest atrakcyjna. Nasi odbiorcy, jak widać, nas nie opuszczają podczas takich dużych wydarzeń. To pokazuje, że w Olsztynie też można robić fajne rzeczy. Nikt nie będzie się dzisiaj nudził. Myślę, że wieczorny koncert przy wahadle Foucaulta będzie muzycznym „huknięciem”. Proponujemy koncert artysty Arne. Przy naszych wydarzeniach łączymy elementy nauki i sztuki. Dziękuję tym, którzy się dzisiaj bawią i świętują.
Uroczystego otwarcia części popołudniowej wydarzenia poza dyrektorem Mateuszem Pikulińskim dokonali prof. Jakub Sawicki, prorektor ds. nauki i współpracy międzynarodowej UWM, prof. Iwona Bogacka, dziekan WBiB, dr hab. Dorota Juchno, prof. UWM, prodziekan ds. studenckich i promocji WBiB, oraz prof. Nina Smolińska, przewodnicząca Rady Naukowej Dyscypliny nauki biologiczne.
Prof. Iwona Bogacka zwróciła uwagę, że w Nocy Biologów uczestniczy wielu absolwentów wydziału.
– To cykliczne święto wszystkich biologów. Wydarzenie ma miejsce w kilkudziesięciu ośrodkach w Polsce. Mam nadzieję, że wszyscy, którzy skorzystają z warsztatów, gier edukacyjnych i pokazów, znajdą to, czego szukają i odpowiedzą sobie na pytania, które zadają na temat komunikacji i sygnalingu między organizmami i wewnątrz nich – zwróciła się do uczestników wydarzenia dziekan wydziału.
Prorektor z kolei zaznaczył, że to również jego, jako biologa, święto.
– Jesteśmy ludźmi o wielu różnych zainteresowaniach. Jedni interesują się ptakami, inni opisują różne gatunki roślin lub zwierząt, inni badają mikroorganizmy albo odkrywają nowe substancje. Tworzymy jedną społeczność – mówił prof. Jakub Sawicki.
Różnorodność zajęć
W tym roku zrezygnowano z wykładów, a organizatorzy zaproponowali same warsztaty oraz stoiska edukacyjne z możliwością przeprowadzenia doświadczeń. Celem było pokazanie, jak teoria działa w praktyce. W ciągu dnia część szkół z odległych miast miała trudności z dojechaniem z powodu zimowej pogody, inne korzystały więc ze zwalnianych miejsc. Wysoką frekwencję miały szczególnie zajęcia popołudniowe.
– Od lat wśród licealistów zainteresowaniem cieszą się zajęcia związane z biologią molekularną, czyli metodami, które odkrywają możliwości DNA. Podczas tych zajęć każdy może przeprowadzić doświadczenie mówiące o tym, czego nie widać, a co decyduje o tym, jacy jesteśmy. Wśród najmłodszych uczestników powiedzeniem cieszą się warsztaty manualne, podczas których dzieci mogą same coś zrobić, dotknąć. Wszystkie zajęcia rezerwowane są bardzo szybko – mówi prof. Dorota Juchno.
Dr hab. Piotr Androsiuk, prof. UWM w części przedpołudniowej prowadził warsztaty Laboratorium genetyczne: izolacja DNA „metodą kuchenną”. W zajęciach uczestniczyła grupa uczniów z Iławy.
– Rozmawiamy o tym, jaka jest struktura DNA i o tym, że występuje w każdym z żywych organizmów. Uczniowie będą mogli samodzielnie przeprowadzić izolację DNA metodą, którą mogliby wykorzystać w domu czy w szkole. Pokażemy także zestawy do profesjonalnej izolacji, które my wykorzystujemy na co dzień. Uczestnicy założą elektroforezę, czyli rozdział DNA w nośniku. Będą pracować z pipetą, odczynnikami. Przejdziemy później do ciemni, gdzie mamy transiluminator – opowiadał prof. Androsiuk na początku zajęć.
Tegoroczny program Nocy Biologów był bardzo bogaty. W części popołudniowej znalazło się w nim miejsce m.in. dla warsztatów z wariografem „Biologiczne sekrety komunikacji – odkrywanie ukrytych sygnałów ciała”. Można było zobaczyć także m.in. stworzone przez pracowników wydziału modele synaps, czyli połączeń komórkowych elektrycznych i chemicznych. Uczestnicy mogli namacalnie sprawdzić, jak wygląda przewodnictwo między komórkami nerwowymi.
Inną propozycją była możliwość zanurzenia krwi w roztworach podczas ćwiczenia edukacyjnego „Komórkowy dialog z wodą: jak erytrocyty reagują na zmianę toniczności otoczenia”.
– Pokazujemy, jak krwinki czerwone, czyli erytrocyty, pobierają tlen i transportują go w naszym organizmie oraz jak odbierają dwutlenek węgla i wydalają go z organizmu. Dodatkowo pokazujemy, jak różne środowisko w organizmie wpływa na budowę tych krwinek, zachowanie, wygląd. Nasze stoisko dotyczy typowej komunikacji w organizmie i kluczowej dla życia – wyjaśniał dr Karol Mierzejewski.
Warsztaty „Biologia na 100%” były propozycją skierowaną do maturzystów.
– Tytuł naszych warsztatów to „Genetyczne śledztwo: Biolog molekularny na tropie przestępstw”. Pokażemy, jak wyizolować materiał genetyczny, jak zbierać ślady na miejscu przestępstw, jak to robią technicy. Na miejscu przestępstw często ich sprawcy zostawiają mało śladów. Będziemy przeprowadzać reakcję łańcuchową polimerazy, czyli będziemy namnażać zebrany materiał. Korzystając z tzw. markerów genetycznych, czyli wskaźników indywidualnych dla każdego człowieka, będziemy w stanie wskazać osobę, która popełniła przestępstwo – opowiadała prof. Nina Smolińska. Warsztaty te już kolejny rok cieszyły się dużym zainteresowaniem.
Dr hab. Anna Biedunkiewicz razem z studentkami ze Studenckiego Koła Naukowego Mykologów budowała na szydełku grzybnię ze strzępek.
– Pokazujemy, że one się ze sobą komunikują i informują w różnych częściach całej grzybni, co się dzieje, Osoby, które do nas przychodzą, mogą wylosować karteczkę z informacją, co trzeba zrobić, czy np. odżywić fragment grzybni albo rozsiać zarodniki. Strzępka rośnie tak, jak nasz szydełkowy łańcuszek. Zapraszamy osoby, które szydełkują albo chcą się tego nauczyć – opowiadała dr. hab. Anna Biedunkiewicz.
Noc Biologów to już tradycja UWM
Joanna Grabowska studiowała na UWM biotechnologię i jako studentka (chwilę przed ukończeniem studiów) była zaangażowana w pierwszą edycję Nocy Biologów. Na 15. edycję przyszła z córką, Julią.
– Moja pierwsza Noc Biologów była współorganizowana z PAN, zajęcia były w jego siedzibie przy ul. Tuwima. Były doświadczenia, wystawy. Cieszę się, że teraz jest możliwość zajęć dla dzieci w Kortosferze. Dzisiaj [w dniu wydarzenia –przyp. red.] wygrałyśmy bilety w konkursie organizowanym na profilu Kortosfery na Facebooku. Jesteśmy stałymi gośćmi tego miejsca. Lubimy takie wydarzenia ze względu na dodatkowe atrakcje, np. wystawy. To jest interesujące dla dzieci, bo mogą zobaczyć coś innego – mówiła Joanna Grabowska, absolwentka UWM.
Zaangażowani w organizację wydarzenia studenci, doktoranci, pracownicy różnych jednostek Wydziału Biologii i Biotechnologii oraz Kortosfery już twórczo planują, co zaproponują mieszkańcom regionu na kolejnych wydarzeniach.
Anna Wysocka
Fot. Katarzyna Wróblewska i Janusz Pająk